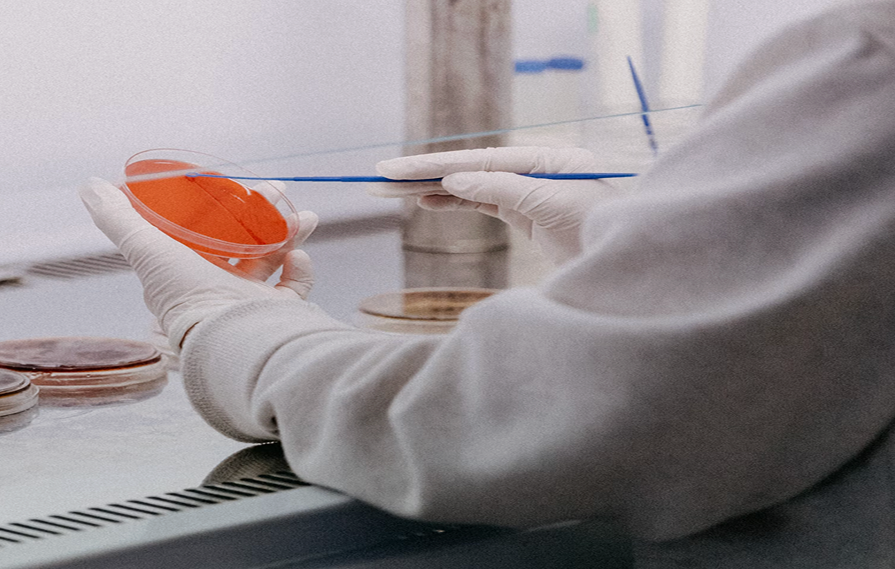

Your cart is empty :(
Continue shoppingYour cart

Save 20–50% on Lab Equipment
Upgrade your lab with high-quality biology lab equipment, medical lab instruments,
and reliable life science testing equipment — all ready to ship.


Biomedical Cold Storage
Beyond Boundaries
From -25°C to -150°C, Haier’s biomedical freezers deliver precise,
reliable storage for critical research and healthcare needs,
ensuring optimal preservation of valuable samples.

Rodent Behavioral
Research Systems
Treadmills, Grip Strength Meters, and RotaRod solutions —
precision tools for motor function, endurance, and coordination studies.




Stand Up Your PCR Workflow
From empty bench to first tests — extraction, PCR, and training in a single bundle, with transparent pricing and no reagent lock-in.
Explore Our Spring Sale
RWD RS-SI Automated Stereotaxic Instrument
RWD Anesthesia Cone Masks for Mouse and Rat
RWD Anesthesia Cone Masks for Mouse and Rat
RWD Anesthesia Cone Masks for Mouse and Rat
RWD Anesthesia Cone Masks for Mouse and Rat
Featured Products
Techman Treadmill Apparatus (Mice/Rats)
Techman Langendorff Perfusion System
Techman Intelligent Micromanipulator
Techman Data Acquisition and Analysis System
Techman Animal Behavior Analysis System
BioPerfectus Measles and Rubella Viruses Real-Time PCR Kit
BioPerfectus Measles Virus Vaccine and Wild-Type Strains Real-Time PCR Kit 50 Tests/Kit
Haier TwinCool Frequency Conversion ULT Freezer
RWD RS-SI Automated Stereotaxic Instrument
RWD FR-11 Dual Color Multichannel Fiber Photometry System
RWD FR-21 Tricolor Multichannel Fiber Photometry System
RWD TAIJI Small Animal Anesthesia Machine
SSNP-2000B Nucleic Acid Extraction System produced by Bioperfectus is a laboratory medical device, which integrates new technologies such as machine, electricity and computer software to enable automatic nucleic acid extraction of 32 samples maximumly in one time.
Shop by Product Line


Anesthesia & Ventilation
Reliable anesthesia and ventilation solutions designed for precise control and safe animal procedures across research applications.


Cold Storage & Cryogenic
Advanced cooling and cryogenic systems for secure sample preservation, ensuring stability and integrity at ultra-low temperatures.


Molecular Diagnostics (IVD)
High-performance tools for accurate molecular detection and analysis, supporting a wide range of research and diagnostic workflows.


Laboratory Equipment
Essential laboratory instruments built for efficiency, reliability, and everyday research operations across diverse applications.
Providing Laboratory & Research Solutions



About Us
We carefully curate trusted brands and proven technologies to provide dependable life science testing equipment and lab instruments for sale that perform consistently in real laboratory environments.
We partner with reputable manufacturers whose products meet recognized quality and safety standards, ensuring every piece of life science analysis equipment supports compliance, accuracy, and confidence in your research.
At BP LabLine, we stay closely aligned with the evolving needs of the scientific community. By collaborating with leading technology partners and listening to researchers, we continuously expand our portfolio of biology lab equipment and advanced life science testing and analysis equipment to support emerging methods and next-generation laboratory applications.
We carefully curate trusted brands and proven technologies to provide dependable life science testing equipment and lab instruments for sale that perform consistently in real laboratory environments.
We partner with reputable manufacturers whose products meet recognized quality and safety standards, ensuring every piece of life science analysis equipment supports compliance, accuracy, and confidence in your research.
At BP LabLine, we stay closely aligned with the evolving needs of the scientific community. By collaborating with leading technology partners and listening to researchers, we continuously expand our portfolio of biology lab equipment and advanced life science testing and analysis equipment to support emerging methods and next-generation laboratory applications.










Our Partners
































































































































































































Excellent Cases
Using fiber photometry to detect the activity of SuM-DG neuronal projections in AD mice
This study establishes the activity-dependent contribution of SuM-enhanced ABNs in modulating AD-related deficits and informs signaling mechanisms mediated by the activation of SuM-enhanced ABNs.


Laser Speckle Imaging System (LSCI), Corroborate haemodynamic changes within the targeted region on the ipsilateral side of the brain before and after stroke in the photothrombotic stroke model.
Use the laser speckle to observe the vascular and haemodynamic changes and blood perfusion in photothrombotic stroke model within the sensory-motor cortex in the acute stages of stroke.

Explore BPLabLine
BPLabLine Services
Trusted Quality Standards
Certified products and carefully evaluated solutions you can rely on.
Trusted Quality Standards
We work closely with trusted suppliers to ensure product quality, compliance, and consistency for research use.
24/7 Tailored Support
Dedicated support tailored to your lab’s needs — before and after purchase.
24/7 Tailored Support
Our team works closely with researchers and procurement teams to provide timely, thoughtful support when it matters.
Simplified Lab Procurement
A centralized way to source equipment, consumables, and lab solutions.
Simplified Lab Procurement
Reduce purchasing complexity with streamlined sourcing designed for research environments.
Reliable Fulfillment
Stable logistics and dependable delivery to keep research moving.
Reliable Fulfillment
We prioritize accuracy and reliability to support uninterrupted lab operations.
Universities and research institutions across New England can now access BP LabLine’s laboratory equipment, research solutions, and scientific consumables through an established MHEC purchasing pathway.




